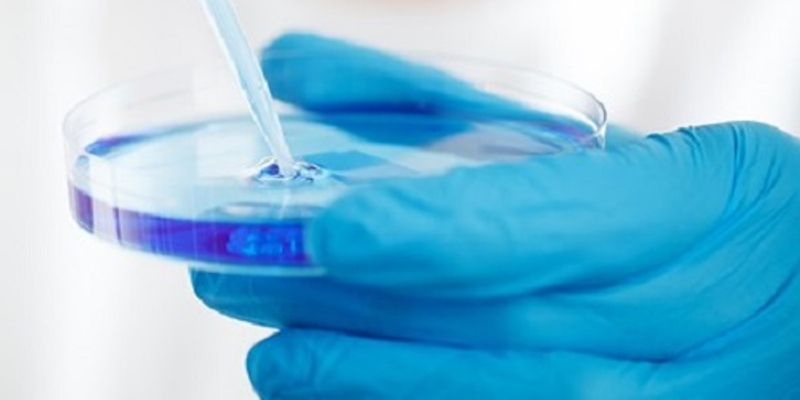

Precision Medicine
Precision Medicine: medical care designed to optimize efficiency or therapeutic benefit for particular groups of patients, especially by using genetic or molecular profiling.
What's Popular in Precision Medicine
-
DEC 12, 2025Genetics & GenomicsIn the 21st century, oncology has achieved extraordinary progress. We can decode a tumor’s genome, tailor therapie ...Written By: Maria PashayanOCT 02, 2025CancerEarlier this week, the National Cancer Institute (NCI) welcomed its 18th Director, the highly esteemed Dr. Anthony Letai ...Written By: Katie KokolusSEP 19, 2025eBooksHuman-relevant models and spatial profiling are transforming drug discovery by providing more predictive, human-like dat ...Sponsored By: Danaher Life SciencesSEP 15, 2025Genetics & GenomicsThe relationship between the gut microbiome and the human body is complex. While the microbes in the human gastrointesti ...Written By: Carmen LeitchAUG 29, 2025eBooksDownload your copy of "Enable precision medicine with comprehensive genomic profiling CGP" eBook to learn more ...
DEC 12, 2025
Genetics & Genomics
In the 21st century, oncology has achieved extraordinary progress. We can decode a tumor’s genome, tailor therapie
...
Written By:
Maria Pashayan
OCT 02, 2025
Cancer
Earlier this week, the National Cancer Institute (NCI) welcomed its 18th Director, the highly esteemed Dr. Anthony Letai
...
Written By:
Katie Kokolus
SEP 19, 2025
eBooks
Human-relevant models and spatial profiling are transforming drug discovery by providing more predictive, human-like dat
...
Sponsored By:
Danaher Life Sciences
SEP 15, 2025
Genetics & Genomics
The relationship between the gut microbiome and the human body is complex. While the microbes in the human gastrointesti
...
Written By:
Carmen Leitch
AUG 29, 2025
eBooks
Download your copy of "Enable precision medicine with comprehensive genomic profiling CGP" eBook to learn more
...
JUN 02, 2025
Clinical & Molecular DX
Scientists have used an analysis of protein expression to learn more about how the body responds to insulin, and problem
...
Written By:
Carmen Leitch
DEC 10, 2024
eBooks
This essential resource will guide you through how microfluidics-based PCR is transforming genomics research, providing
...
Sponsored By:
Standard BioTools
DEC 03, 2024
Immunology
Join us to explore the latest insights into the future of precision oncology! This year, the Agilent Precision Oncology
...
SEP 17, 2024
eBooks
Monoclonal antibodies (mAbs) have revolutionized targeted cancer therapies with unmatched specificity and potency. Since
...
-
DEC 09, 2025 | 10:00 AMEnsuring quality and compliance is at the core of every successful clinical laboratory. This webinar brings together CAP expert Daniel and Christie, QA leader from Burning Rock, to explore t...Speaker: Daniel Chen - M.D., Ph.D. , Christina Brown - CGMBS, MB(ASCP)Sponsored By: Burning Rock DxDEC 01, 2025 | 4:00 PMThis webinar offers a unique opportunity to hear directly from Professor Mathias Uhlén, lead author of the recent Science publication introducing the human pan-disease blood atlas. Bu...NOV 20, 2025 | 10:00 AMDiscover how intelligent assistants at Merck are transforming the way scientific teams engage with complex datasets. This webinar will demonstrate how researchers can intuitively explore and...SEP 17, 2025 | 8:00 AMSeer’s novel approach to mass spectrometry-based proteomics can reveal layers of biological information invisible to other methods, offering the potential for transformative insights....JUL 31, 2025 | 8:00 AMC.E. CREDITSExplore the insights shared at ASHG 2024 on MVP-ROAR and AutoMitoC—now available on-demand. This Educational Session underscores the value of healthcare-linked biobanks and computation...
DEC 09, 2025 | 10:00 AM
Ensuring quality and compliance is at the core of every successful clinical laboratory. This webinar brings together CAP expert Daniel and Christie, QA leader from Burning Rock, to explore t...
Speaker:
Daniel Chen - M.D., Ph.D.
, Christina Brown - CGMBS, MB(ASCP)
Sponsored By: Burning Rock Dx
DEC 01, 2025 | 4:00 PM
This webinar offers a unique opportunity to hear directly from Professor Mathias Uhlén, lead author of the recent Science publication introducing the human pan-disease blood atlas. Bu...
NOV 20, 2025 | 10:00 AM
Discover how intelligent assistants at Merck are transforming the way scientific teams engage with complex datasets. This webinar will demonstrate how researchers can intuitively explore and...
SEP 17, 2025 | 8:00 AM
Seer’s novel approach to mass spectrometry-based proteomics can reveal layers of biological information invisible to other methods, offering the potential for transformative insights....
JUL 31, 2025 | 8:00 AM
C.E. CREDITS
Explore the insights shared at ASHG 2024 on MVP-ROAR and AutoMitoC—now available on-demand. This Educational Session underscores the value of healthcare-linked biobanks and computation...
July 31, 2025 7am PST/10am EST/4pm CET
microRNAs are emerging as powerful biomarkers for precision medicine, offering valuable insights into disease mechanisms, diagnosis, prognosis, and treatment response. However, successful di...
MAY 28, 2025 | 8:00 AM
Join us for an insightful session where we explore how NGS proteomics is transforming our understanding of health and disease. Discover how proteomics integrates seamlessly with genomics, me...
APR 16, 2025 | 7:00 AM
Join us for a live webinar on the latest advancements in spatial biology. Featuring two insightful presentations, learn how cutting-edge imaging and single-cell technologies are transforming...
Speaker:
Tarek M. Ashkar (El-Achkar), MD
, Sarah Teichmann, Ph.D.
, Dr. Andrea Radtke
Sponsored By: Leica Microsystems
APR 10, 2025 | 7:00 AM
Psoriatic arthritis (PsA) is a chronic inflammatory disease affecting the joints, entheses, and skin, while also increasing the risk of cardiovascular disease (CVD) and metabolic dysfunction...
-
Labroots is excited to announce our 14th Annual Precision Medicine: Genomics, Genetics & Molecular Diagnostics Virtual Event Series 2026 held on April 29th, 2026! The Precision Medicine:...Experience the forefront of pharmaceutical innovation as Labroots and the Drug Discovery and Development planning committee host the 10 th Annual Drug Discovery & Development Virtual Eve...Labroots is excited to announce our 15th Annual Precision Medicine: Genomics, Genetics & Molecular Diagnostics Virtual Event Series 2027 held on May 12th, 2027! The Precision Medicine: G...DEC 05, 2025C.E. CREDITSStago EdVantage Virtual University is an educational platform that demystifies hemostasis testing with on-demand webinars and a virtual exhibit hall that ......NOV 05, 2025EVENT BROADCAST INFORMATION: Wednesday, November 5th, 2025 (Click below to add broadcast to your calendar) Europe + Nordics + Middle East + Africa: 11:00am CET | 12:00pm EET North America +...
Labroots is excited to announce our 14th Annual Precision Medicine: Genomics, Genetics & Molecular Diagnostics Virtual Event Series 2026 held on April 29th, 2026! The Precision Medicine:...
Experience the forefront of pharmaceutical innovation as Labroots and the Drug Discovery and Development planning committee host the 10 th Annual Drug Discovery & Development Virtual Eve...
Labroots is excited to announce our 15th Annual Precision Medicine: Genomics, Genetics & Molecular Diagnostics Virtual Event Series 2027 held on May 12th, 2027! The Precision Medicine: G...
DEC 05, 2025
C.E. CREDITS
Stago EdVantage Virtual University is an educational platform that demystifies hemostasis testing with on-demand webinars and a virtual exhibit hall that ......
NOV 05, 2025
EVENT BROADCAST INFORMATION: Wednesday, November 5th, 2025 (Click below to add broadcast to your calendar) Europe + Nordics + Middle East + Africa: 11:00am CET | 12:00pm EET North America +...
OCT 08, 2025
| 8:00 AM PDT
Join us at the Olink Proteomics Conference , a novel platform for scientists exploring the latest advancements in proteomics and proteogenomics on immunology, oncology, neuroscience, ageing,...
MAY 14, 2025
| 5:30 AM PDT
C.E. CREDITS
Labroots is excited to announce our 13th Annual Precision Medicine: Genomics, Genetics & Molecular Diagnostics Virtual Event Series 2025 held on May 14th, 2025! The Precision Medicine: G...
APR 02, 2025
| 8:00 PM PDT
Oncomine World is back with brand NEW features Now in its sixth year, OncomineWorld meetings have united thousands of scientists and professionals from around the globe to advance genomic pr...
SEP 25, 2024
| 11:30 PM PDT
Join us at the Olink Proteomics Conference , a novel platform for scientists exploring the latest advancements in proteomics and proteogenomic on immunology, oncology, neuroscience, ageing,...